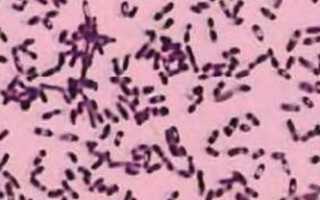
Иерсиниоз: как проявляется и лечится кишечная инфекция?

Иерсиниоз — что это такое? Симптомы и способы лечения Иерсиниоз – это патология инфекционной природы, которая провоцируется поступлением в восприимчивый организм специфического возбудителя, провоцирующего развитие патогномоничной клинической картины, свидетельствующей о поражении того или иного органа.
Инфекционистами в ходе многочисленных лабораторных исследований удалось идентифицировать семь видов иерсиний, однако, не все они являются патологически опасными для людей. Возбудитель иерсиниоза по морфологическим свойствам сходен с возбудителями чумы и псевдотуберкулеза.
Возбудитель иерсиниоза
Возбудитель и его факторы патогенности (способности вызывать заболеваемость):
- Грамм отрицательная палочка (при окраске по грамму окаршивается в розовый цвет), цвет которой говорит о наличии капсулы;
- Также есть жгутики, которые обуславливают активное передвижение после внедрения в организм;
- Так же есть адгезин, связывющийся с коллагеном, в результате чего возникает артрит;
- Способность к синтезу сериновой протеазы, которая обеспечивает разрушение секреторного IgA слизистых и облегчает проникновение через защитный барьер, т.к именно IgA является линией первой защиты на слизистых оболочках (и не только кишечника).
- Как и у псевдотуберкулёза, у возбудителя кишечного иерсиниоза есть белки наружной мембраны, обеспечивающие проникновение через слизистую оболочку кишки неинвазивным путём (т.е без нарушения целостности кишечной стенки).
Эпидемиология
Естественный резервуар для иерсиний — почва. Животным и птицам отводят роль вторичного резервуара и источника инфекции. Основные из них — грызуны, сельскохозяйственные животные (например, свиньи, рогатый скот, кролики), птицы и домашние животные (кошки, собаки).
Основной механизм передачи заболевания — фекально-оральный. Человек инфицируется при употреблении воды и продуктов, контаминированных иерсиниями (овощи, молоко, молочные продукты). На территориях с жарким климатом около 80% всех вспышек связано с питьём заражённой воды. Описаны случаи иерсиниоза после переливания инфицированной крови. Восприимчивость высокая. К группам риска относят лиц, работающих в животноводстве, птицеводстве и на пищеблоках. ИИП среди населения в разных регионах составляет 10–20%.
Постинфекционный иммунитет внутривидовой.
Иерсиниоз регистрируют повсеместно. Наиболее часто — в странах Западной и Северной Европы, в Великобритании, США, Канаде, Японии и России, реже — в Африке, Азии, Южной Америке и Восточной Европе. Фактическая заболеваемость в России значительно выше, чем официально регистрируемая. Подъём начинается в марте и продолжается 4–5 мес, резко снижаясь к августу и повторно возрастая в конце года.
Причины возникновения
Бактерия, которая вызывает кишечный иерсиниоз достаточно жизнеспособна в условиях окружающей среды. Иерсинии устойчивы к холоду, легко выдерживают заморозку и последующее размораживание, долгое время живут в воде и почве. Но солнечный свет, кипячение, высушивание и химические средства для дезинфекции губительны для бактерий этого рода..
В процессе своей жизнедеятельности бактерии выделяют 3 вида токсинов: энтеротоксин, цитотоксины и эндотоксин.
Иерсиниозная инфекция распространяется в большей степени от животных: грызунов, домашних животных (преимущественно свиньи), собак. Заражение от инфицированного человека встречается крайне редко.
Способ заражения фекально-оральный по средствам продуктов питания и воды. К основным причинам возникновения заболевания относится:
- продукты питания животноводства, которые прошли недостаточную термическую обработку;
- вода, в которую попали испражнениями больных животных;
- плохая гигиена, при которой возможен бытовой путь инфицирования.
Факторы, способствующие заболеванию
Существует ряд факторов, которые способствуют возникновению заболевания:
- чаще возникает иерсиниоз у детей. В детском возрасте заболевание протекает намного тяжелее;
- ослабленный иммунитет;
- различные заболевания в хронической форме.
Виды
Исходя из ведущих проявлений инфекции, иерсиниоз можно разделить на несколько форм:
| Гастроинтестинальная | при которой поражаются желудок с развитием гастрита, толстая кишка и аппендикс. |
| Генерализованная | при которой поражается весь организм с развитием сепсиса, поражением печени, почек, оболочек головного мозга и легких. |
| Смешанная | с поражением двух и более органов, например – печени и почек. |
| Вторично-очаговая | это поражение суставов, мышцы сердца, кишечника, кожи на фоне ранее протекавшей инфекции. |
Прогноз
Иерсиниоз – заболевание, которое имеет большое количество осложнений, но, несмотря на это прогноз благоприятный. Случаи летального исхода встречаются довольно редко.
Неблагоприятным исход заболевания встречается при септической форме заболевания, где смертность встречается в 50% случаев.
Иерсиниоз – достаточно коварное заболевание, которое требует незамедлительной медицинской помощи. Особое внимание заслуживают дети. В детском возрасте, в большинстве случаев заболевание проходит в тяжелой форме.
Заболевание имеет разные симптомы и лечение у взрослых и детей, зависит от формы и степени тяжести заболевания.
Для исключения заражения следует соблюдать все меры по профилактике заболевания. А в случае если появились симптомы, указывающие на наличие болезни, нужно незамедлительно обращаться к врачу. Важно помнить своевременно оказанная медицинская помощь – залог выздоровления без осложнений.
Очень важно не заниматься самолечением, заболевание невозможно вылечить без медицинской помощи. Перед приемом любых средств необходима консультация специалиста.
Псевдотуберкулез и иерсиниоз
Псевдотуберкулезом называют патологию, которая также как иерсиниоз, вызывается микроорганизмами той же разновидности. Клиническая симптоматика у этих болезней похожая, особенно, когда пациент страдает тяжелым поражением желудочно-кишечного тракта и суставов. При развитии данных патологий одинаково наблюдается сыпь на руках и на ногах. Нередко врачам очень сложно внешне отличить иерсиниоз от псевдотуберкулеза, поэтому назначаются лабораторные исследования.
Псевдотуберкулез имеет свой период инкубации, который продолжается примерно 1-2 недели. В первую очередь пациентов с таким диагнозом начинает мучить симптомы общей интоксикации, выраженные в виде головной боли, покраснения и отечности горла, боли в суставах и мышечных тканях. Больной замечает на языке покрытие грязно-серого цвета. Таким язык бывает у людей, страдающих скарлатиной.
Когда болезнь переступает 2-4 недельный рубеж, появляется сыпь на теле, которая представляет собой мелкие красные точки. В большинстве случаев такие высыпания проходят спустя 7 дней, а после своего исчезновения оставляют следы в виде чешуйчатого шелушения.
Терапия псевдотуберкулеза заключается также в приеме антибиотиков, препаратов, устраняющих симптомы интоксикации, а также гормональные средства. Таким образом, данные инфекционные заболевания имеют сходства, поэтому правильный диагноз ставится только после проведения всех необходимых диагностических мероприятий.
Обычное течение
Надо сказать. Что иерсиниоз довольно распространенное инфекционное заболевание.Чаще всего он протекает под видом обычной кишечной инфекции,заканчивается выздоровлением в течение 5-7 дней .
Естесственно, что далеко не всегда проводится этиологическая расшифровка, поэтому примерно 20-30% иерсиниозов проходит мимо статистики.
Симптомы иерсиниоза
Инкубационный период – это время от начала внедрения возбудителя в организм до первых клинических проявлений, при иерсиниозе может длиться от 15 часов до 6 суток, но чаще 2-3 дня. В этот период через желудочно-кишечный тракт возбудитель проникает в кишечник, где фиксируется и размножается.
Там он захватывается тканевыми макровагами, часть его погибает, выделяя эндотоксин, а часть разносится этими же макрофагами (из-за незавершённого фагоцитоза) по лимфоидной системе, а потом и по кровеносной – вызывая диссеминацию, что я вляется пусковым механизмом для возникновения периода клинических проявлений. Длительность инкубационного периода и течение всех остальных процессов будет зависеть от следующих факторов: иммунологической реактивности организма, от штамма и инфицирующей дозы возбудителя, от пути проникновения.
Симптомы иерсиниоза у взрослых во многом напоминают гастроэнтерит, гастроэнтероколит, энтероколит, терминальный илеит.
Для кишечного иерсиниоза характерны боль в животе, которая может иметь постоянный или схваткообразный характер, рвота, тошнота, зловонный понос. Стул во время болезни может быть от 2 до 15 раз в сутки, с примесью гноя, слизи, а иногда и крови.
Симптомы иерсиниоза, помимо поражения кишечника, свидетельствуют еще и об общей интоксикации организма – повышение или понижение температуры, обезвоживание, токсикоз. Для начала болезни в некоторых случаях характерно появление мелкопятнистой или точечной сыпи на конечностях и туловище, также в этот период иерсиниоза может наблюдаться менингеальный синдром и поражение печени.
Для более позднего периода данной инфекции характерно развитие таких заболеваний, как узловатая эритема, моно- или полиартрит, ирит, конъюнктивит, миокардит, синдром Рейтера.
Кишечный иерсиниоз может длиться от одной недели до нескольких месяцев. [adsense2]
Методики
Лабораторная диагностика включает в себя большое количество исследований, о которых мы и поговорим.
Анализ крови на иерсиниоз – это наиболее информативный метод исследования
ИФА
В основе этого метода лежит специфическая реакция антиген-антитело. Для его проведения необходимо сдать венозную кровь. Забор биологического материала проводится натощак. Показаниями к проведению анализа крови являются такие симптомы:
- боль и вздутие живота;
- диарея с примесями крови и слизи;
- кожная сыпь;
- повышение температуры тела до отметки 39–40 0C;
- лихорадка;
- ломота в мышцах и суставах.
Внимание! Расшифровкой анализа занимается квалифицированный специалист.
Анализ проводится с целью дифференциальной диагностики острых кишечных инфекций. Положительный результат указывает на наличие текущего острого кишечного иерсиниоза или раннее перенесенное заболевание. Сомнительные результаты может давать недавно перенесенная инфекция или ранняя стадия патологического процесса. В этом случае исследование следует повторить через одну-две недели.
Общий и биохимический анализ крови
Биологический материал после забора помещается в специальные вакутайнеры. В общем анализе лаборанты обращают внимание на показатели кровяных клеток, гемоглобина, гематокрита, а также скорости оседания эритроцитов. При иерсиниозе может наблюдаться анемия. Также показатели СОЭ и лейкоцитов повышаются. При биохимическом исследовании определяется концентрация ферментов, белков, минеральных веществ и продуктов обмена в крови.
В общем анализе крови обнаруживается анемия, а также сдвиг лейкоцитарной формулы
Генетический анализ
В качестве биологического материала может быть взята кровь, кал, рвотные массы. Суть метода основывается на выявлении ДНК-возбудителя инфекционного заболевания. Одним из преимуществ ПЦР-диагностики является высокая точность. Объясняется это следующими причинами:
- корректный забор и транспортировка биоматериала;
- использование стерильного и одноразового инструментария;
- соблюдение стерильности;
- строгое соблюдение правил и этапов методики.
Микробиологическое исследование
С помощью этой методики можно выделить в чистом виде возбудителя инфекции. Для анализа берется кровь, фекалии, смывы с глотки, рвотные массы и другое. Биологический материал помещают в специальные среды, в которых создаются благоприятные условия для активного развития инфекционного агента.
Итак, ранняя диагностика иерсиниоза – это залог успешного лечения. Обследование пациента начинается со сбора анамнеза и осмотра пациента. Натолкнуть врача на мысль о наличии заболевания может кожная сыпь, пищеварительные расстройства, интоксикация, желтуха.
Точный диагноз ставится на основании результатов лабораторных исследований. Выявить возбудителя заболевания можно при помощи бактериологического посева. Методика имеет ряд недостатков, поэтому его назначают в комплексе с другими анализами. Высокой точностью являются серологические и иммунологические методы исследования.
Иерсиниоз может вызвать серьезные осложнения и стать причиной смертельного исхода. Чтобы этого избежать, уже при появлении первых симптомов обращайтесь к специалисту. Не пускайте болезнь на самотек, особенно это касается маленьких детей. Внимательное отношение к своему организму может даже спасти жизнь. Ваше здоровье – в ваших руках!
Диагностика
Заподозрить иерсиниоз может врач-терапевт или врач скорой помощи, но окончательный диагноз устанавливает инфекционист.
Для подтверждения диагноза необходимо обнаружить микроб в фекалиях, крови, желчи, моче или спинномозговой жидкости. Можно провести бакпосев мокроты или смывов с ротоглотки.
Выделение возбудителя сложное и требует до 30 суток. С целью экспресс-диагностики применяют определение антигенов возбудителя в биологических секретах.
При иерсиниозе необходимы консультации специалистов:
- гастроэнтеролога,
- кардиолога,
- невролога,
- нефролога.
Необходимо проведение ЭКГ, ультразвукового исследования сердца и органов брюшной полости.
Осложнения
При данном заболевании осложнения могут носить самый разнообразный характер. Сюда могут относиться различного типа воспалительные органные заболевания (гепатит, миокардит, панкреатит, холецистит), патологии хирургического характера (кишечная непроходимость, спаечная болезнь, перитонит и т.д.).
Не исключаются и заболевания ЦНС (к примеру, менингоэнцефалит), опорно-двигательного аппарата (остеомиелиты, артриты и т.п.), заболевания мочевыделительной системы (гломерулонефрит).
Лечение иерсиниоза
В современной клинической практике иерсиниоз лечат стационарно, назначая пролонгированные этиотропные средства даже при легких формах заболевания. Такая тактика обуславливается частотой хронизации инфекции и развитию рецидивирующего характера течения. Этиотропная терапия включает курс антибиотиков и фторхинолонов, продолжительностью на весь лихорадочный период и 10-12 дней после.
Позднее назначение препаратов (после 3 дней клинической симптоматики) не гарантирует предупреждения осложнений и хронизации инфекции. Генерализованную форму лечат комплексно (назначают препараты различных групп антибактериальных средств парентерально), для профилактики рецидивов производят смену антибиотиков на протяжении курса.
Комплекс неспецифических терапевтических мер выбирается в зависимости от состояния больного и течения заболевания. По показаниям назначают дезинтоксикационные растворы (декстран, коллоидные и кристаллоидные смеси), антигистаминные препараты, противовоспалительные группы нестероидных средств, а при необходимости – преднизолон (нередко используют гормональные противовоспалительные средства для местного применения). Больным может быть показана витаминотерапия, пищеварительные ферменты, пробиотики для коррекции кишечного биоценоза, а также средства для повышения иммунной защиты (иммуномодуляторы, человеческий иммуноглобулин). [adsense3]
Классификация
Заболевание проявляется себя достаточно разнообразно, отличается внушительной скоростью возникновения симптомов и развития осложнений. Вот почему до сих пор нет четко установленной и принятой единой классификации иерсиниоза. Чаще всего врачи используют классификацию Ющука, включающую в себя четыре основных типа инфекционного заболевания:
- гастроинтестинальная;
- абдоминальная;
- генерализованная;
- вторично-очаговая.
Чаще всего у детей появляется кишечный иерсиниоз
Гастроинтестинальный
Является наиболее распространенной формой иерсиниоза. Проявляется в виде болей животе, тошноты, рвоты, диареи, озноба, вялости. Также у ребенка могут появляться катаральные признаки, склерит, конъюнктивит, а также проблемы с мочеиспусканием. Для гастроинтестинальной формы характерно легкое или среднетяжелое течение.
Абдоминальный
Напоминает по своим проявлениям острый аппендицит. Ребенка беспокоят боли в околопупочной области, которые опускаются в правую подвздошную часть живота. Развивается патология при проникновении болезнетворных микроорганизмов в лимфатические узлы брюшины. При проведении оперативного вмешательства обнаруживается флегмонозно-гангренозный аппендицит.
Внимание! Детям часто ставят неправильный диагноз «острый аппендицит».
Профилактика иерсиниоза
В каждом государстве существуют и активно работают органы, которые уполномочены осуществлять санитарно-эпидемиологический надзор за соблюдением санитарных норм, которые направлены на распространение иерсиниоза. Постоянно должны проводиться профилактические мероприятия, направленные на предупреждение возможности контаминации иерсиний на продуктах питания, которые подлежат длительному хранению, например, овощах.
Овощи должны храниться на специальных овощехранилищах, оборудованных таким образом, что не допускается попадание в них грызунов, являющихся главными переносчиками иерсиний. Все стеллажи и полки в овощехранилищах подлежат обязательной регулярной дезинфекции с последующим проветриванием помещения. Эффективность дезинфицирующих мероприятий оценивается только путем забора лабораторных проб с поверхностей овощехранилища, в которых должны полностью отсутствовать иерсинии даже непатогенного серотипа. Немаловажным значением обладает поддержание определенного микроклимата в овощехранилищах (температура воздуха 4о°С и относительная влажность до 70%).
Больные, перенесшие иерсиниоз, подлежат выписке из стационара не только после устранения клинических проявлений заболевания, но и полной нормализации лабораторных маркеров иерсиниоза, особенно это касается кишечной формы. Бактерионосители иерсиний подлежат амбулаторному лечению. С целью предотвращения распространения инфекции, бактерионосители и больные иерсиниозом лица, работающие на пищеблоках, отстраняются от работы на период медикаментозного лечение.
Дети, которые перенесли иерсиниоз, после выписки из инфекционного стационара, обязательно подлежат диспансеризации у участкового педиатра, так как данная патология склонна к развитию хронизации процесса и появлению рецидивов. Лица, относящиеся к декретированным группам по иерсиниозу, обязаны пройти полное лабораторное обследование перед выпиской из стационара, включающее не только биохимические показатели, но и анализ кала на наличие иерсиний.
Клинические рекомендации
Профилактические меры позволят сохранить здоровье пациента, если будет соблюден правильный образ жизни. Чтобы снизить риск развития кишечного иерсиниоза в организме, нужно выполнять клинические рекомендации:
- Взрослый и ребенок обязаны следить за своей личной гигиеной. Если пренебрегать этим правилом, то возникают благоприятные условия для размножения патогенных микроорганизмов, способных нарушить функциональность кишечника.
- Нужно придерживаться правил приготовления продуктов питания животного происхождения. Также требуется правильно хранить пищу.
- Со всей серьезностью к профилактическим мерам должны относиться не только люди в повседневной жизни. Следить за профилактикой обязаны сотрудники детских, пищевых и лечебных структур. Они должны производить контроль за качеством источников воды, наличием грызунов. Также необходимо предотвратить размножение микробов и бактерий в пищевых продуктах, которые нуждаются в длительном хранении.